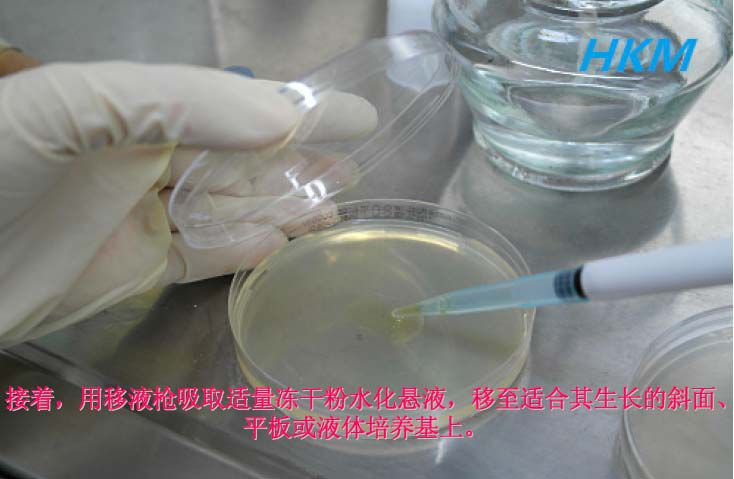
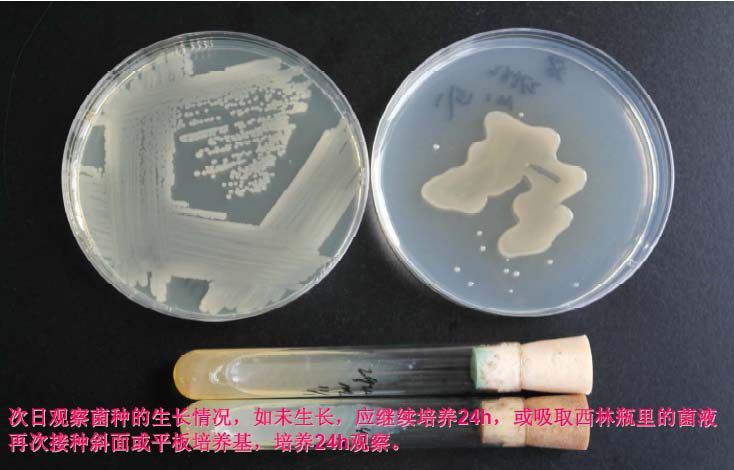
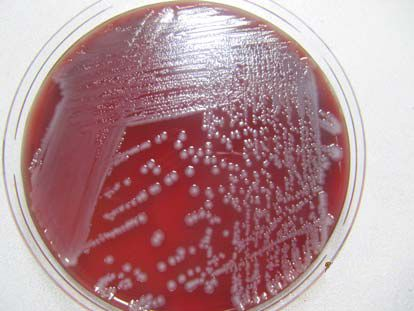

微生物质控菌种复苏、保藏、使用及管理
发布时间:2019-10-11 浏览次数:18367
微生物实验室如果从事致病菌检测、培养基质控验收、方法验证等相关工作,就应该备有质控菌株。实验室需对使用的质控菌株进行规范性管理,以便有效地、安全地使用,保证实验结果的准确性,今天我们从冻干菌种的复苏确认、质控菌种的保藏和使用、菌种管理要求、菌种接收和登记四个方面为大家详解实验室质控菌种保藏、使用及管理。
一、冻干菌株的复苏确认
1、图解冻干菌株复苏具体操作

准备开启复苏冻干菌种的所有实验用品:酒精灯、75%消毒酒精棉、移液枪、接种环、培养基、冻干菌种(注意:所有操作应在符合生物安全保护及无菌条件下进行)

开启冻干菌种西林瓶时,用75%酒精棉消毒西林瓶表面。

然后,在无菌条件下,按铝盖上的箭头方向打开塑盖,撕开铝盖,打开西林瓶胶塞。

用移液枪向冻干质控菌种西林瓶加入0.3ml左右的配套液体培养基,水化冻干粉,将冻干质控菌种溶解成为均匀的悬液。
用移液枪吸取适量冻干粉水化悬液,移至适合其生长的斜面、平板或液体培养基上。

或者,用接种环蘸取适量冻干粉水化悬液。

接种斜面

或平板划线接种(便于观察菌落形态)

接种完后,在器皿上标记菌种编号、传代数、日期等信息。

倒置放进恒温培养箱培养。

最后,将转接的斜面或平板以及西林瓶里剩余的菌悬液放置于36°C培养箱中进行培养
次日,观察菌种的生长情况,如未生长,应继续培养24H,或吸取西林瓶里的悬液再次接种斜面或平板培养基,培养24H观察。
2、冻干菌株复苏补充说明
1)志贺氏菌、阪崎肠杆菌、肺炎克雷伯氏菌、阴沟肠杆菌、产气肠杆菌、奇异变形杆菌、普通变形杆菌、小肠结肠炎耶尔森氏菌、粘质沙雷伯氏菌、弗氏柠檬酸杆菌、铜绿假单胞菌、芽孢杆菌类、大肠埃希氏菌、沙门氏菌、金黄色葡萄球菌、表皮葡萄球菌、藤黄微球菌:复苏水化液为脑心浸液培养基,复苏培养基为营养琼脂,复苏培养条件37±1℃培养基培养24h-48h。
2)粪链球菌、乙型溶血性链球菌:复苏水化液为脑心浸液培养基,复苏培养基为血平板,复苏培养条件37±1℃培养基培养24h-48h。
3)VB0非01群霍乱弧菌:复苏水化液为碱性蛋白胨水,复苏培养基为碱性琼脂,复苏培养条件37±1℃培养基培养24h-48h。
4)副溶血性弧菌、创伤弧菌:复苏水化液为3%NaCl碱性蛋白胨水,充分悬浮后放置于37±1℃下复苏8-12小时;再转接培养基为3%NaCl营养琼脂,培养条件37±1℃培养基培养24h-48h。
注意事项:
由于副溶血性弧菌、创伤弧菌对低温比较敏感,在冻干保存过程中菌量数级下降,因此需要先增菌后转接,否则会复苏失败。
5)单核细胞增生李斯特氏菌:复苏水化液为脑心浸液培养基,复苏培养基为血平板或胰蛋白胨大豆酵母浸膏琼脂(TSA-YE),复苏培养条件37±1℃培养基培养24h-48h。
6)生孢梭菌、产气荚膜梭菌:复苏水化液为脑心浸液培养基,复苏培养基为疱肉牛肉粒肉汤加液体石蜡1cm(隔绝空气营造厌氧环境),复苏培养条件37±1℃培养基培养24h-48h。
7)空肠弯曲菌:复苏水化液为布氏肉汤,复苏培养基为血平板,复苏培养条件42±1℃微需氧条件下培养48-72h。
8)两歧双歧杆菌、婴儿双歧杆菌:复苏水化液为TPY肉汤,复苏培养基为BBL琼脂,复苏培养条件42±1℃厌氧环境下培养48-72h。
9)德氏保加利亚乳杆菌:复苏水化液为MSR肉汤,复苏培养基为脱脂奶粉溶液(10%),复苏培养条件37±1℃培养基培养24h-48h。
10)黑曲霉、桔青霉、绳状青霉、白色念珠菌、啤酒酵母:复苏水化液为沙氏液体培养基,复苏培养基为马铃薯葡萄糖琼脂(PDA),复苏培养条件25-28℃培养基培养2-5天。
温馨提示:
• 冻干菌株复苏需要一个最适生长环境,复苏培养基不能选用选择性培养基或显色培养基,这些培养基里面含有抑菌成分不利于菌株复苏。
• 冻干菌种为一次性使用品,开启之后不能反复使用或保存,暂不开启的菌种应在4℃保藏。
3、菌株纯度检查和确认
菌落形态:单菌落在分离平板上的特征
细胞形态:镜检
芽胞大小、位置、性状
生化鉴定
如有杂菌污染,需划线分纯。
二、质控菌种的保藏和使用
1、质控菌株的使用
1)定量菌液制备(比浊法)
• 将纯度满意的新鲜培养物悬浮灭菌生理盐水中;
• 以灭菌生理盐水调整、制备成0.5麦氏(McFarland)浊度的菌悬液,备用;
• 使用时稀释至合适的稀释度。

2)麦氏(McFarland)比浊标准管的配制

例如,需配大约100cfu/mL 的细菌菌液浓度:
• 无菌操作用接种环挑取测试细菌的纯培养物到盛有一定量无菌生理盐水管中,混悬。
• 以比色卡作为背景目测,直到浊度与0.5 麦氏比浊标准管的浊度相一致,如右图所示。
• 0.5 号麦氏浊度标准管相当于1×10^8CFU/mL 浓度,以此为参照值,取1mL 浊度跟0.5 号麦氏浊度标准管相一致的菌悬液到9mL 无菌生理盐水管中,作10 倍梯度稀释10^7、10^6、10^5……,10^2 稀释度含菌量大约为100cfu/mL。
注:
1)测试菌的纯培养物可以是冻干菌株复苏后纯培养物。
2)本法仅供细菌液浓度的粗略计算。
2、菌种的保存
• 确定适宜的保藏方法。
• 同一菌株应选用两种或以上方法进行保藏。
• 只能用一种方法保存的菌株应备份存放于两个以上保藏设备中。
• 菌种入库和出库应记录入档。
• 重要菌种应异地保存备份。
3、菌种保存方法
1)传代培养法:复苏后的第一代放于4℃冰箱或室温保存,定期传代培养。保藏时间依微生物种类而定。如,芽孢、霉菌、酵母菌保存6个月转一次,普通细菌1个月转一次,假单胞菌2周转一次。
2)液体石蜡法:将无菌石蜡加在长菌的斜面或半固体上,高出斜面顶端1cm为准,隔绝空气,试管直立,置于低温或室温保存。芽孢、霉菌、酵母菌保存2年,普通细菌1个月至1年。
3)甘油冻存法:将复活后经过性能确认的菌株新鲜培养物(一般是第二代菌株),用0.85%的灭菌生理盐水(约1-2ml)洗斜面菌苔成菌悬液;将上述菌悬液吸取适量于灭菌管(冻存管)中(如,灭菌管容量为5ml,则取1.5ml菌
液),加入等体积的40%灭菌甘油,混匀,密封。保藏温度为—20℃,一般可保存1-2年。
4)瓷珠保存管保存:菌株保藏管内含特制的小珠(20-25颗)和特殊溶液,只需将培养好的菌株接入溶液中,摇匀成菌悬液,细胞即吸附于小珠上,然后吸出溶液,将保藏管置-70℃可保存5年,置-20℃可保存2-3年。
瓷珠保存管保存具体操作:
第一步:对需要保存的菌株进行必要的纯化,挑取生长旺盛时期的菌落,接入菌株
保藏管中,通常需要接入4-7环,对于苛养菌应多接一些;
第二步:拧上盖子,充分剧烈震荡;
第三步:用无菌吸管将溶液吸走,尽可能吸干;
第四步:马上放入冰箱中,温度越低越有利于保存(推荐使用-70℃超低温冰箱);
第五步:复苏时,只需将小珠在平板上滚动或置肉汤中培养。
注:
1. 尽可能避免反复冻融,对于一些苛养菌和厌氧菌这样做可能会影响保存效果;
2. 很多情况下,复苏须对菌株纯度检查,必要时做生化鉴定,以确认无污染。
瓷珠法保存操作:

瓷珠保存后活化操作:

三、菌种管理要求
• 实验室的装备和管理:防护水平与操作对象危险程度相适应
• 制定菌种使用、保藏管理制度和标准化操作规程菌种申购、保管、领用、使用、传代、存储等,确保溯源性和稳定性
• 建立文件记录,做好纸质和数字化信息档案备份菌名、编号、来源、鉴定特征、鉴定者、传代情况、最适培养基和培养条件、保藏方法和保藏位置等
• 保藏菌种容器表面贴上标签
• 保存菌株应制备成储备菌株和工作菌株,定期传代,每次传代至少对菌种进行形态学观察
• 菌种管理专人负责:菌种保藏、复核鉴定和使用管理
四、菌种接收和登记
• 获得途径:购买、交换、接收赠送。
• 来源:专门的菌种保藏机构,如美国典型培养物保藏中心(ATCC)菌株或商业来源的ATCC演化菌株。
• 记录菌株号、菌名、来源、数量、生产日期、接收日期等信息。






